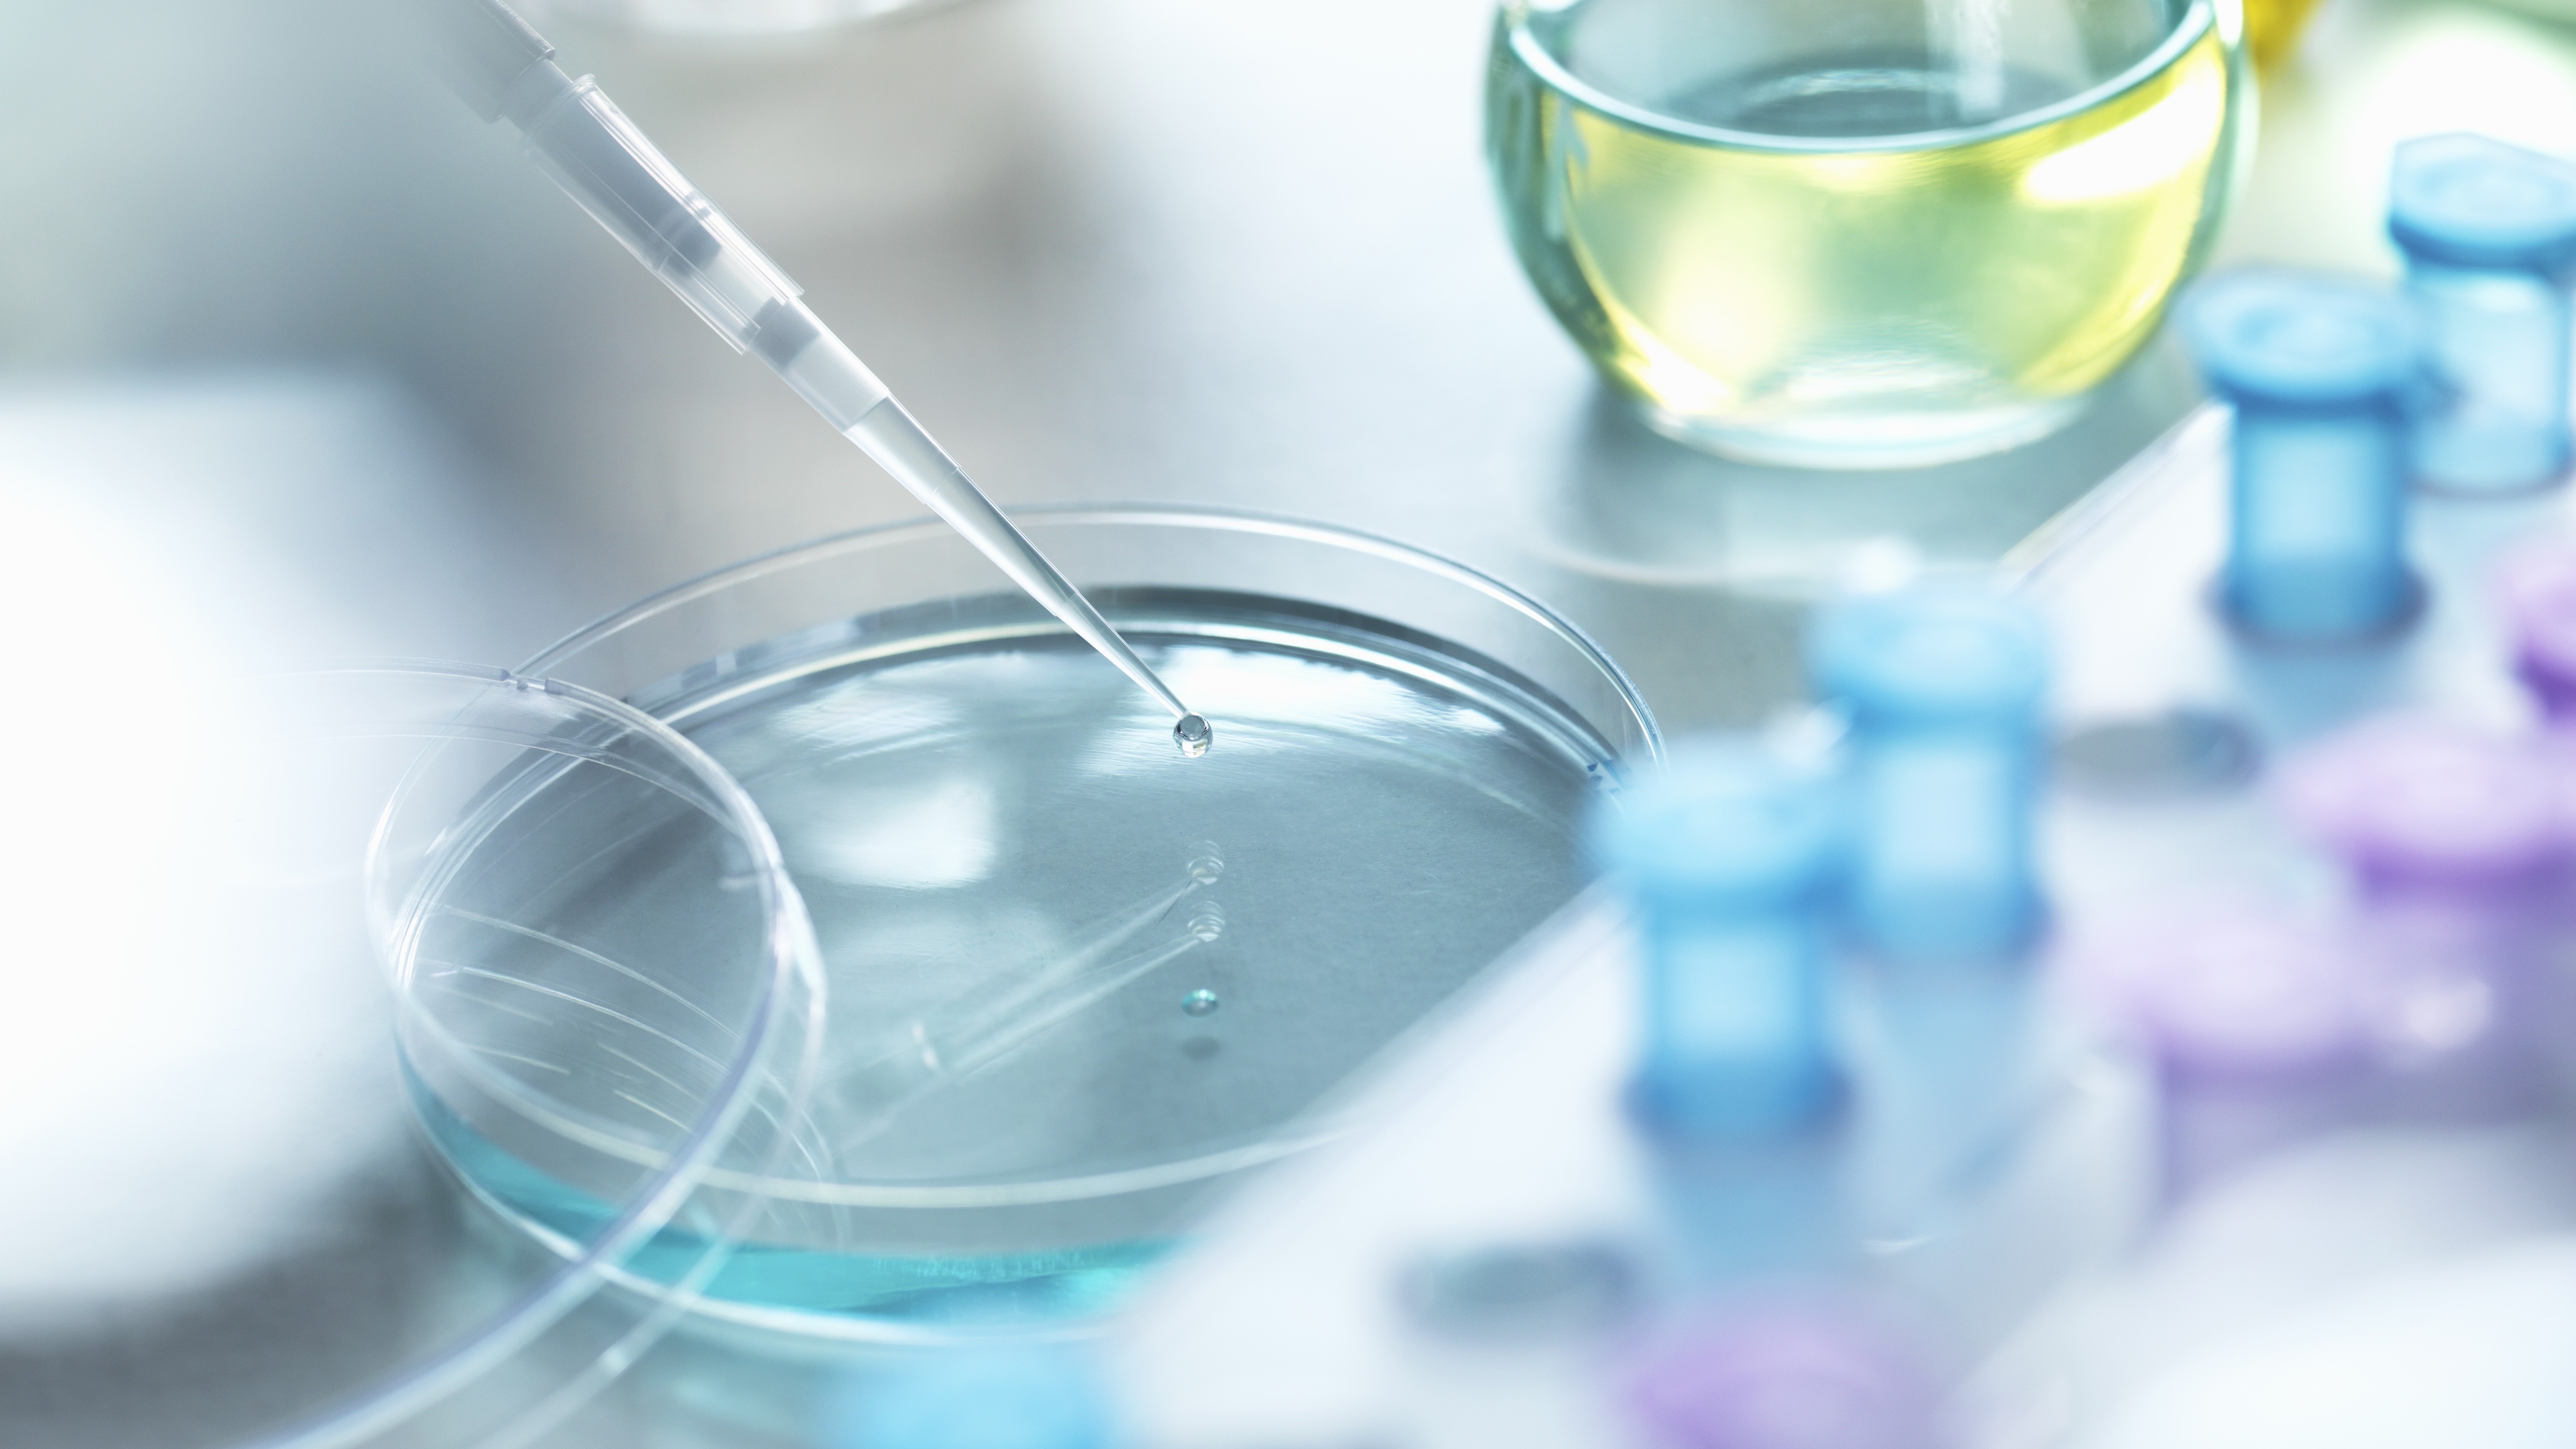

7月16日,中国国家知识产权局副局长卢鹏起在京会见美国药品研究与制造企业协会(PhRMA)副总裁何凯文一行,双方就中国药品知识产权保护方面的法律法规及政策举措进行了深入交流。
卢鹏起表示,中国政府高度重视知识产权保护,始终坚持对内外资企业的知识产权一视同仁、同等保护。近年来中国不断完善法律法规及相关制度,这些新制度将为中外制药企业知识产权保护提供更大支持。国家知识产权局愿意倾听各界声音,推动构建更加公平公正、开放透明的创新环境和市场环境。
何凯文对近年来中国药品知识产权保护取得的进展表示赞赏,就具体政策分享了意见和建议,并希望与中国知识产权部门持续深化交流。
中国国家知识产权局相关部门负责人参会。
—
来源:国家知识产权局
全文转载自国家知识产权局,请点击查看原文。